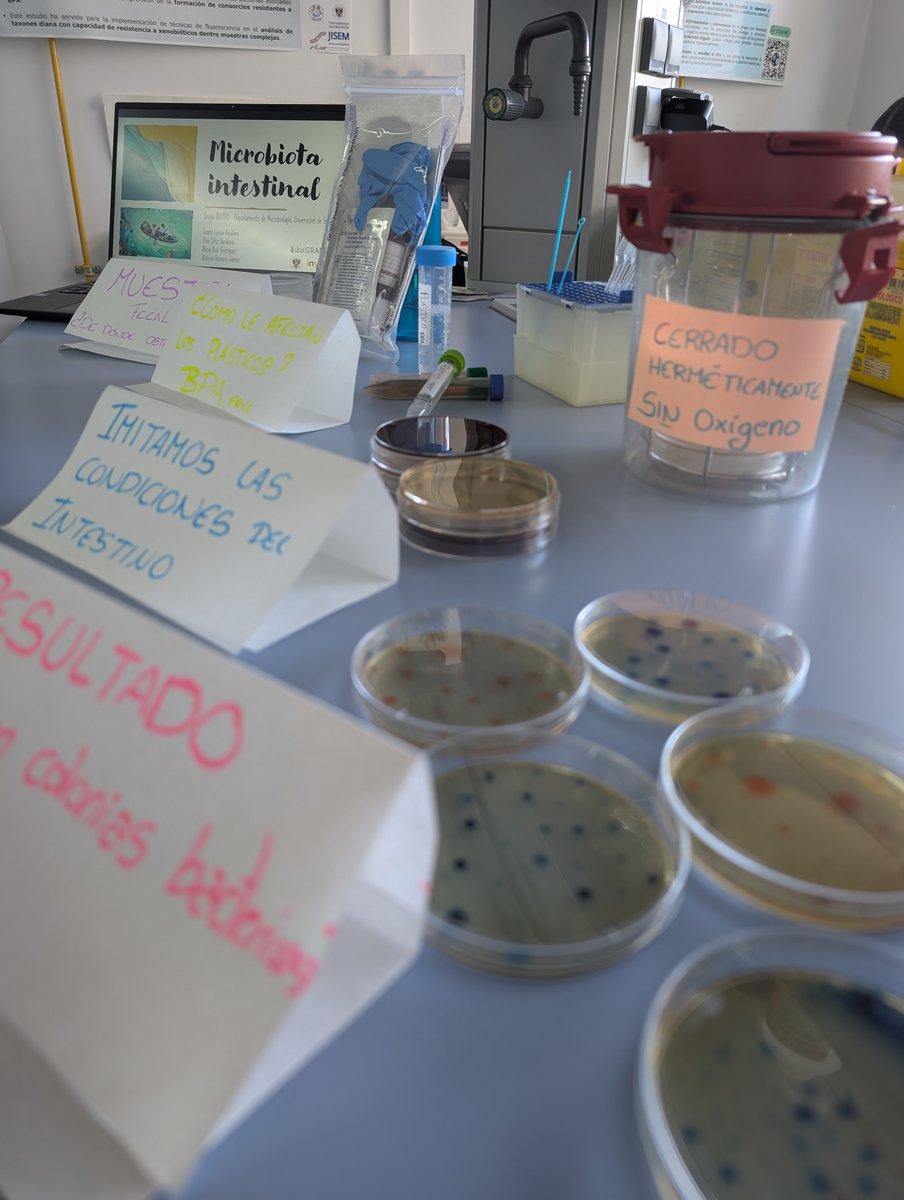
MicroBIOta UGR tweet media

Centro de Investigación Biomédica retweetet

▶️ Estamos en Granada, en el foro #InnovaU junto a @CanalUGR, @Wayra, Cátedras de Telefónica.
Vamos a hablar de #innovación abierta, #investigación y #emprendimiento en #salud a los universitarios para inspirarles y mostrarles salidas laborales

Español